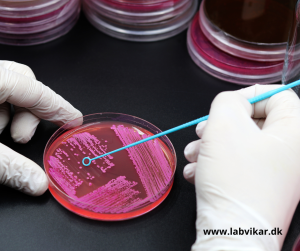

BESAT: Laborant til Midtjylland
LabVikar søger for kunde en laborant til et vikariat.
Virksomheden ligger ca. 30 km. syd for Randers.
Vikariatet strækker sig fra uge 30 til 35, 2 dage om ugen med arbejdstid mandage og onsdage fra kl. 08.00 – 12.00 begge uger inkl.
Vi ønsker en laborant, som har et par års praktisk erfaring med mikrobiologiske analyser.
Hvis dette har fanget din interesse, så send straks din ansøgning til katja@labvikar.dk
Vi indkalder løbende til samtaler.
Og husk at kun kandidater, som er fuldt oprettede i vores database, kommer i betragtning.
Se tjekliste for oprettelse her: Tjekliste – LabVikar
LabVikar ApS
Avernakøvænget 4
5000 Odense C